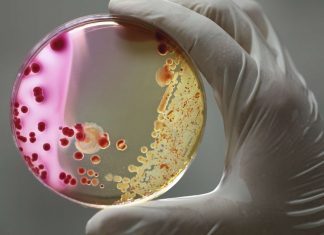
Bactérie Escherichia coli : les autorités sanitaires insistent sur la prévention Bactérie Escherichia coli : les autorités sanitaires insistent sur la prévention

Pas-de-Calais: Un adolescent de 14 ans se tue au volant à Beuvry, près de...
Une voiture a violemment percuté un arbre dans la rue Delbecque à Beuvry dans la nuit de lundi à mardi. Le conducteur, âgé de...
Bactérie Escherichia coli : les autorités sanitaires insistent sur la prévention
Après un premier décès signalé en février, les autorités appellent à renforcer la prévention. Les autorités sanitaires s'inquiètent de la mort d'un deuxième enfant...
Eric Zemmour : qui est Mylène Chichportich, sa femme et mère de ses trois...
Eric Zemmour est officiellement candidat à la Présidentielle, après avoir laissé planer le doute depuis plusieurs semaines. S'il sait faire parler de lui dans...
Sondages présidentielles 2022 récents: Zemmour et Mélenchon devant Pécresse
Selon le sondage présidentiel de l’Institut BVA pour RTL et Orange d'aujourd'hui, Emmanuel Macron obtient au premier tour 30% (+1) des intentions de vote.
Il...
Dordogne : un adolescent de 16 ans se tue en scooter
Un jeune de 16 ans a perdu la vie au guidon de son scooter dans un accident qui s’est produit sur la D 64,...
Sondage présidentielle premier tour 2022, Emmanuel Macron creuse encore l’écart
Selon le dernier sondage BVA, Marine Le Pen est créditée de 17% des intentions de vote, Éric Zemmour est à 13% et Jean-Luc Mélenchon...
Dernier sondage elections présidentielles 2022 : Valérie Pécresse continue sa chute
À un mois du premier tour de la présidentielle, les sondages donnent une orientation claire. Un schéma qui semble se répéter par rapport à...
Elections présidentielles 2022 : patrimoine et intérêts des 12 candidats publiés
Les déclarations de patrimoine et d’intérêts des 12 candidats à la présidentielle, publiées mardi par la Haute autorité pour la transparence de la vie...
Koh-Lanta 2022 : Samira éliminée à l’issue de l’épisode 3
L’ancienne handballeuse professionnelle a été évincée par ses camarades de l’équipe rouge fraîchement composée, dans le troisième épisode de «Koh-Lanta : le totem maudit»,...
Derniers sondages elections présidentielles 2022 : Emmanuel Macron progresse de 8,5 points
Un nouveau sondage Opinion 2022 réalisé par l'institut Elabe reflète les intentions de vote au premier tour de la présidentielle.
Au 1er tour, Emmanuel Macron...